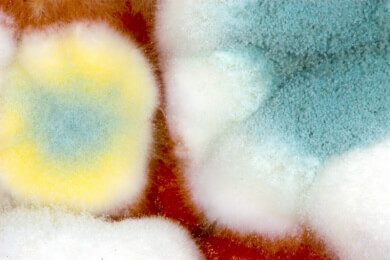
Getreide: Giftige Gefahr Mykotoxine

Verzicht auf Gluten um Übergewicht zu vermeiden - sinnvoll oder unnötig?
In dem ganzen Berg an Diättipps und -formen hat sich mittlerweile der Trend durchgesetzt, auf Gluten zu verzichten. Dabei handelt es sich um ein Klebereiweiß, welches sich in zahlreichen Getreideprodukten findet und angeblich selbst bei gesunden Menschen zu Krankheiten und Übergewicht führen kann. Doch ist der Verzicht auf Gluten wirklich sinnvoll und seine angeblichen Auswirkungen wahr?
Experten zufolge entsprechen diese Gerüchte nicht der Wahrheit. Gesunde Menschen können das Eiweiß ohne Bedenken verzehren. Allerdings sollte man es nicht übertreiben, denn der übermäßige Verzehr von Getreideprodukten wie Kuchen, Gebäck und Co. kann hingegen sehr wohl zur Gewichtszunahme führen - allein das Gluten ist dabei jedoch nicht schuld.
Auch wer bewusst auf eine glutenfreie Ernährung achtet, kann zunehmen, denn wenn Hersteller auf dieses Eiweiß verzichten, bedienen sie sich meist an zusätzlichen Fett oder Zucker, um die richtige Konsistenz des Produktes zu erhalten.
Gluten bei Zöliakie und Glutenempfindlichkeit
Neben den Menschen, die sich trotz Gesundheit für den Verzicht von Gluten entschieden haben, gibt es auch die Gruppen, die das Eiweiß nicht vertragen, wie zum Beispiel bei einer Zöliakie. Dabei handelt es sich um eine chronische Erkrankung, die zu Verdauungsbeschwerden, Blutarmut oder auch Osteoporose führen kann.
Weiterhin sind die Gluten-sensitiven Menschen zu nennen, die jedoch, wie neueste Forschungen ergeben, nicht unbedingt auf das Klebereiweiß allergisch reagieren, sondern vielmehr auf ATI, einen Insektenabwehrstoff natürlichen Ursprungs, welcher in vielen Getreidesorten vorkommt.